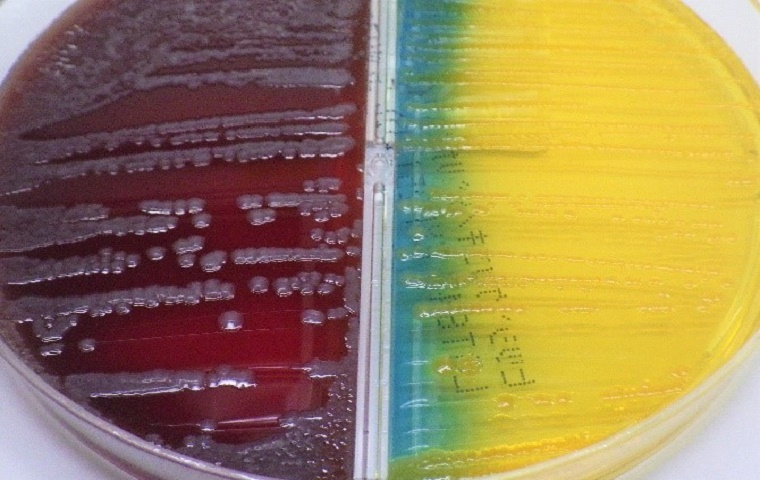
培地に発育した大腸菌

部門の特色

当検査室は2025年11月にISO15189を取得
しました!!
臨床検査科は国際規格である「ISO15189(臨床検査室-品質と能力に関する特定要求事項)」の認定を取得しました。
【ISO15189とは?】
臨床検査室に特化した国際規格であり、品質管理システム(QMS)と技術的能力を評価し、国際的に通用する正確で信頼性の高い検査結果の提供を保証するものです。この規格の認定を取得することで、検査の品質と技術的能力が国際的な基準に達しており、信頼性の高い検査結果を提供していることの証明になります。今後も信頼性のある検査結果を提供していくために、認定の維持に努めていきます。
(生理検査は認定範囲外)
臨床検査科目標
- 国際規格ISO15189認定を維持継続し、患者さんに質の高い正確な臨床検査を提供します。
- 医療安全、感染対策、情報セキュリティ対策に取り組み、より安全安心な業務を行います。
-
人材育成の一環として所属学会の研修会参加、専門資格取得および学会発表に積極的に取り組みます。
- 病院経営に貢献する業務改善に取り組みます。
診療内容
臨床検査科技師長よりメッセージ
佐久総合病院グループ臨床検査科は佐久総合病院(本院)・小海分院・佐久医療センターの3施設で情報共有および連携を図る事を常に心がけています。そして各施設のスタッフはそれぞれの施設の特徴を理解し、日々の業務に取り組んでいます。
昨今の医療の高度化や専門化にともない、臨床検査の将来を見据えた検査機器の導入や更新、またスタッフの認定資格取得など資質向上や人材育成にも力を注いでいます。
有資格者一覧(2026年4月現在)
| 資格名称 | 認定団体名 | 人数 |
| 検体採取等指定講習修了 | 日本臨床衛生検査技師会 | 19 |
| タスク・シフト/シェア指定講習修了 | 日本臨床衛生検査技師会 | 14 |
| 細胞検査士 | 日本臨床細胞学会 | 6 |
| 国際細胞検査士(IAC) | 国際細胞学会 | 5 |
| 認定病理検査技師 | 日本臨床衛生検査技師会 | 3 |
| 認定輸血検査技師 | 日本輸血・細胞治療学会 | 2 |
| 感染制御臨床微生物検査技師 | 日本臨床微生物学会 | 1 |
| 認定臨床微生物検査技師 | 日本臨床微生物学会 | 1 |
| 医用質量分析認定士 | 日本医用マススペクトル学会 | 1 |
| 認定骨髄検査技師 | 日本検査血液学会 | 1 |
| 認定血液検査技師 | 日本検査血液学会 | 2 |
| 超音波検査士 循環器 | 日本超音波医学会 | 1 |
| 超音波検査士 泌尿器 | 日本超音波医学会 | 1 |
| JABTS乳癌検診従事者認定(A判定) | 日本乳癌検診精度管理中央機構認定 | 1 |
| 精度管理責任者 | 日本臨床衛生検査技師会 | 2 |
| 細胞治療認定管理士 | 日本輸血・細胞治療学会 | 1 |
| NST専門療法士 | 日本臨床栄養代謝学会 | 1 |
| 二級臨床検査士 微生物 | 日本臨床検査同学院 | 2 |
| 二級臨床検査士 血液 | 日本臨床検査同学院 | 3 |
| 二級臨床検査士 臨床化学 | 日本臨床検査同学院 | 1 |
| 二級臨床検査士 病理 | 日本臨床検査同学院 | 6 |
| 二級臨床検査士 循環生理 | 日本臨床検査同学院 | 1 |
| 二級臨床検査士 呼吸生理 | 日本臨床検査同学院 | 1 |
| 心電図検定 | 日本不整脈心電学会 | 1 |
| 緊急臨床検査士 | 日本臨床検査同学院 | 3 |
| 日本糖尿病療養指導士 | 日本糖尿病療養指導士認定機構 | 1 |
| 有機溶剤作業主任者 | 厚生労働省労働基準局 | 4 |
| 特定化学物質・ 4アルキル鉛等作業主任者 |
厚生労働省労働基準局 | 4 |
| 化学物質取扱責任者 | 長野県労働基準協会連合会 | 1 |
| 保護具着用管理責任者 | 長野県労働基準協会連合会 | 2 |
| 危険物取扱い者乙種4類 | 消防試験研究センター | 1 |
| 遺伝子分析科学認定士(初級) | 日本臨床検査同学院 | 1 |
認定施設
- 輸血機能評価認定制度(I&A制度)認定施設
- 認定臨床微生物検査技師制度 研修認定施設
- 日本臨床細胞学会教育研修施設認定
- 日本臨床細胞学会施設認定
- 日本病理学会研修認定施設認定
外来採血室(外来4番)
毎日平均320名程の採血を行っています。
特別な治療の方に対応できるように、朝8時より早出体制を組み対応しています。
一般の患者さんは8時15分より外来採血開始となります。午前の混雑時には看護師・検査技師が5〜6名体制で採血を行っています。
採血室では外来受付とは別に、採血の受付が必要となります。採血室入口に設置してある採血受付機で受付を済ませてから採血室にお入りください。

- 患者様にお願い
・患者さんのご本人確認のために、氏名と生年月日を採血前に名乗っていただくお願いをしています。院内で何度も確認を行いますが、患者間違いをなくすためご協力をお願い致します。
・採血により血液検体で様々な検査を行うことができますが、末梢血の血管に針を刺しますので痛みを伴います。我々はできる限り患者様の負担にならないよう細心の注意を払い穿刺致しますが、針を刺すことにより指先がしびれたり鋭い痛みを感じたときは遠慮無くおっしゃってください。
・採血・検尿検査結果には1時間ほど掛かります。予約時間の1時間前に病院にお越しいただき受付を行った上で採血室にお越しください。予約制の病院のため予約時間より1時間以上前に来院されても診察の順番が早まる訳ではございません。朝の受付・採血の混雑緩和にも予約時間1時間前の来院にご協力をお願いします。

血液検査
血球算定や末梢血液像・骨髄像の観察、凝固線溶検査、血小板凝集能検査、クロスミキシング検査(交差混合試験)、赤血球沈降速度などを行っています。このような検査は各種血液疾患の診断・治療経過判定・経過観察などの目的で行われます。
- ・血球算定検査:赤血球、白血球、血小板などの数や、ヘモグロビン濃度、ヘマトクリット値を測定します。これらの数値から、貧血や炎症の有無、出血傾向などを調べます。
- ・末梢血液像:血液の塗抹標本を作成し、目視及びDI60(血液像自動分析装置)で白血球を分類し、赤血球・血小板の形態の観察を行います。白血病や悪性リンパ腫などの異常細胞の有無や出現率を調べる検査です。
- ・骨髄像:造血の場である骨髄の塗抹標本を作製し、細胞の種類、性状、比率、形態を観察します。血液疾患の診断において極めて重要な検査となります。
- ・凝固検査:血液の固まりやすさを調べる検査で、出血傾向や血栓症のリスクを評価します。また他に血小板機能を調べる血小板凝集能検査、血液の凝固時間が延長している原因を特定するために行われるクロスミキシング検査(交差混合試験)を行っています。
- ・赤血球沈降速度:体内の炎症や組織破壊の程度を反映する、非特異的な指標です。特定の病気を診断するものではなく、病態のスクリーニングや、病気の活動性の経過観察に用いられます。





一般検査
尿検査や便潜血、体腔液(胸水・腹水・髄液)などの検査を行っています。
- ・尿定性検査:試験紙を使って尿中に出ている成分を調べます。
- ・尿沈渣:遠心分離した尿の沈殿物を顕微鏡で観察し、赤血球、白血球、扁平上皮細胞の数、細菌、結晶、異型細胞などの有無を調べます。
- ・便潜血検査:便に混じった微量の血液を検出し、大腸がんや消化管からの出血の有無を調べます。
- ・便虫卵検査:回虫やぎょう虫などの寄生虫の卵や虫体がないか調べます。
- ・髄液検査:腰椎から採取した髄液を調べ、髄膜炎や脳出血などの診断に用います。
- ・体腔液検査:胸腔や腹腔にたまった液体を分析し炎症や腫瘍の診断に役立てます。
生化学・免疫血清検査
- 血液は全身を巡っているので、体のどこかに不調となる原因があると、血液中にその原因が出てくることがあります。血液中にはまだ分かっていないものも含めて、非常に多くの成分が含まれています。
- その成分(項目)を測定することで、体に異常がありそうかどうか、もし分かればどこに異常がありそうか調べることができます。そのような理由から、まずは異常を見つけ出す目的で他の検査を行う前に血液検査を行うことがあります。血液は血球と液体の成分(血清や血しょう)に大別されますが、生化学検査・免疫血清検査は血清などを使って検査を行います。測定したい項目に合わせて、化学反応を応用した試薬でその量を測定したり、ヒトに備わっている免疫反応を応用した試薬を用いて測定したりします。
- 基本的にこれらの項目は日本全国のどこの病院に行って検査しても、非常に精度良く同じ値が出るように管理されているため、他の病院や検査所で検査した結果と比較することができます。当検査科では100種類以上の項目を測定できるように管理しており、できるだけお待たせしないように、装置の故障などが起きても測定を止めないように努めています。測定方法が異なると装置が別で必要となることがありますが、同じメーカーの装置を連結して使用することで測定に関する様々な作業工程を省力化しています。また、急なトラブルが発生しても測定を24時間365日滞ることがないように、ほぼミラーリングした装置をバックアップ用として配置し、普段は測定結果を可能な限り早く報告するために2台で測定を行っています。
診療日は、外来入院合わせて600人程度の患者さんの検査を行っており、2~3人のスタッフで対応しています。診療に必要な結果を、誰が検査しても同じ質が保てるように努めており、今後も維持していきます。

当院で導入している生化学測定装置と免疫測定装置を直列させたハイブリッド測定装置
蛋白分画検査
血清中の様々な種類のタンパク質は、特定の条件で電気を流すと+や-に荷電することが知られています。また、その荷電の強さと、特殊なゲルに塗布して電気を流したとき、タンパク質とゲルの間の摩擦の強さの程度によって、陽極から陰極までそれぞれのタンパク質が異なる場所まで移動することが知られています。これらの性質を利用して、血液中のタンパク質の全量を可視化して、肝臓で主に作られるタンパク質の質や量を評価することができます。しかしながら、どのタンパク質がどのくらい存在しているかまでは分かりません。技術が進歩して、測定したいタンパク質を直接測ることができるようになったため、近年あまり目にすることはなくなりました。
一方で、血球の成分うち、リンパ球と呼ばれる細胞の仲間が免疫グロブリンを産生することが知られています。この免疫グロブリンもタンパク質なので、一緒に検査することができます。まれにこのリンパ球ががん細胞となってしまい、病的に特定の免疫グロブリンが増えすぎてしまうことがあります。その場合、クローン化された免疫グロブリンが多量に産生されるため、特徴的な“バンド”として現れます。このように、病的なタンパク質を探したり、治療の効果を判定したりする目的でも測定されています。同様の方法で、本来は尿中に排泄されることのないタンパク質が尿中に排泄されている場合についても検査することがあります。
輸血検査
安全な輸血療法を行うための血液型や交差適合試験、不規則抗体の有無等を検査する部署です。輸血療法とは手術や病気、けがなどで不足した血液成分を補充する臓器移植の一種とされる治療法です。

輸血療法は命に関わる状況を救う有効な治療法ですが、全くリスクがないわけではありません。そのリスク(輸血副反応)を低減するために検査を行い、自動輸血検査装置やシステムを介し、ヒューマンエラーが起こらないような仕組みも構築しています。輸血後の管理も行うことにより、予測のつかない輸血副反応にも医師の指示の元、対応する部署です。
輸血が必要になりえる手術の際は、前もってご自身の血液を貯血し保管しておく業務にも携わっています。
血液疾患の治療法の一つである末梢血幹細胞の保管・管理も1名の細胞治療認定管理師を中心に行っています。
日本輸血・細胞治療学会認定技師2名を含む、技師2名が毎日の専従技師として業務に当たり、年間約RBC7000単位 FFP3000単位 PC10000単位を院内で安全に使用しています。
夜勤帯には認定技師の指導の下、緊急輸血にも対応できる教育プログラムに従い、教育を受けた技師が他の検体検査などと同様に24時間止まらない検査室として輸血検査にも従事しています。さらに毎日夜間待機者1名を確保し、緊急輸血・多発外傷などの緊急時には呼び出し体制も整えています。
そして、当検査室一番のポイントは、日本輸血・細胞治療学会が定める基準に基づき、病院において患者さんの安全を確保し、適切な輸血医療を提供し、適切な輸血管理が行われている日本輸血・細胞治療学会より認定された、I&A認定施設であるということです。(2025年10月現在 長野県唯一の認定施設)

微生物検査
人に感染症を起こす病原体は、目では見えない「病原微生物」と呼ばれます。この目では見えない病原体を様々な方法で増やし、その病原体が何なのかを突き止める検査が微生物検査です。
細菌を染める事の出来る「グラム染色」を行い、顕微鏡で拡大して菌を見る事で感染症の原因菌を探します。
また、細菌が好む組成を寒天で固めた作られた培地と呼ばれるシャーレに検体材料を塗り1晩孵卵器で培養すると菌が生えてきます。

培養で発育してきた菌が「何の菌なのか?」を決める事を「同定検査」と言います。
当院では質量分析計という、短時間かつ高い精度で菌名が得られる装置を導入しています。熱で苦しむ患者さんをいち早く治療できる様、検査体制を整えています。
菌名が決まったら、最後に細菌感染治療に用いられる抗菌薬(抗生剤)と菌を混ぜて培養し、菌に効果のある抗菌薬を選ぶ「薬剤感受性試験」を行います。こうして迅速で適正な抗菌薬治療に結び付く検査を日々心掛けています。


遺伝子検査
細菌は培地で菌を増やす事が出来ますが、ウイルスは増やす事が出来ません。そこでPCRという装置を使って遺伝子を増幅させる事で何のウイルスが悪さをしているかを探します。
通常のPCRでは1つの検査で1つのウイルスしか検査出来ませんが、当院では「マルチプレックスPCR」という装置を導入し、一度の検査で複数のウイルスがいるかがわかる検査体制を整えています。
また、多くのPCR検査は1時間~3時間と時間の掛かるものが多いですが、通称「迅速
PCR」と呼ばれる約20分で結果が得られる装置を備え、迅速な感染症診断に貢献しています。


生理検査
生理検査とは患者さんの身体に直接接して心臓、脳、肺などの臓器や器官の機能を調べる検査です。病気の診断や病状の進行度の確認、治療方針・治療効果などを目的としています。多くの検査は患者さんに大きな苦痛を与えることなく検査できます。
当院では、心電図、超音波検査、肺機能検査、脳波検査、神経伝導速度検査、血圧脈波検査、心肺運動負荷試験などを行っています。

循環機能検査
・心電図検査
ベッドに寝てもらい、胸部に6個、両手首、両足首に電極を付け、心臓が動く際に発する微弱な電気信号を様々な方向から波形として記録します。検査時間は数分で痛みを伴うことはありません。脈拍が乱れていないか、心臓の筋肉が厚くなったり、大きくなっていないか、狭心症や心筋梗塞などを調べます。


・ホルター心電図
携帯用の小型心電計を使って、長時間(24時間)心電図を記録します。日常生活を送りながら不整脈など安静時ではとらえられない異常を特定するために行います。胸部に4か所電極を貼って機械を持ち歩いてもらいます。検査中は普段通りの生活を送れますが、シャワーや入浴はできません。また強い電気や電磁波は検査に影響しますので、控えていただくようになります。


・足関節上腕血圧比(CAVI・ABI・TBI)
両腕と両足首、足の指に血圧のカフと胸に心音マイクを装着します。ABIは足首と上腕のTBIは足の指と上腕の血圧の比を計算することで下肢動脈や末梢動脈の狭窄や閉塞の程度を表します。CAVIは心臓から足首までの動脈の硬さを調べる検査です。
検査時間は5~10分程度で痛みはありません。

・心臓運動負荷試験(CPX)
自転車をこぐ運動をしながら、心臓、肺、筋肉の状態を評価する検査です。心電図、血圧計、口と鼻にマスクを装着して運動中の息のガスを測定し体にどれくらい効率良く酸素を取り込み使えるか、また運動にどこまで耐えられるかを調べます。
息切れの原因や狭心症など運動によって現れる心臓病や、心不全などの重症度評価、心臓リハビリテーションなどの運動療法を行った後の効果の評価ができます。

・呼吸機能検査
息を吸ったり吐いた入りしてもらって肺の働きを調べる検査です。主にぜんそくなどの 呼吸器の病気の診断や治療効果の判定、また全身麻酔での手術が可能かを判断するため に行われます。患者さん本人に大きく吸ったり吐いたり、勢いよく吐いてもらうため、 患者さんの協力が不可欠な検査です。


・超音波検査
人間の耳には聞こえない超音波を体に当て、返ってくる超音波を画像化して臓器や病変の状態を見る検査です。検査部位は腹部、心臓、乳腺、甲状腺、血管など様々な部位が可能ですが、超音波が通りにくい骨や空気を含む臓器は難しい場合があります。痛みや被爆がなく、安全な検査でリアルタイムに観察できます。検査部位によっては、食事をすることで臓器や病変が見えなくなってしまうこともあるため、食事や水分制限などの事前準備が必要になります。


脳・神経機能検査
・脳波検査
頭皮に多数の電極を貼り付けて脳の電気信号を波形にします。検査は1~2時間程度で痛みを伴うものではありません。この検査では、てんかん、脳腫瘍など脳の疾患や脳の機能を評価するために行います。

・神経伝導検査
手足の末梢神経に弱い電気刺激を与え、その刺激が神経を伝わる速さや信号の大きさを測定し神経の機能障害を評価する検査です。しびれや痛み、筋力低下などの症状の原因を調べ、神経障害の部位や程度の特定に役立ちます。
病理検査
病理検査室の使命-確かな診断が最良の治療へ
病理検査室は、患者さんから採取された組織や細胞を顕微鏡で観察し、病気の本質を診断する部門です。病理医、臨床検査技師、事務職員が協力し、質の高い病理診断を提供しています。組織診断、細胞診断、迅速診断、解剖業務を通じて、臨床現場を支援しています。
私たちは「見えないところ」から患者さんの命を守ります。
組織診断
病理組織検査は、大きく分けて生検材料と手術材料に分けられます。
①生検材料
病変の一部を採取して診断をつけるための検体で、主に診断目的で実施されます。これには胃・大腸・肺などの内視鏡生検や乳腺・肝臓などの針検体、皮膚検体などが含まれます。病理では腫瘍かどうか、良悪性の判定、腫瘍の組織型などが求められます。生検検体は検体量が少ないため、時に限られた情報で診断をしなければなりません。壊死や出血、非腫瘍部が採取された場合、診断が困難なこともあります。また必要に応じて免疫組織化学や電子顕微鏡検査、分子病理解析を用いて診断しています。可能な限り迅速で正確な診断報告ができるように最善を尽くします。
②手術材料
病変を全摘または部分切除した検体で、主に確定診断、病期ステージ決定、根治性の評価を目的とします。これには胃・肺・乳房・子宮などの全摘出や部分切除があり、時に周囲臓器やリンパ節の切除も含まれます。病理では広がりや悪性度の評価、切除断端の評価、脈管や神経周囲への侵襲の有無、リンパ節転移の有無をみて、腫瘍の最終診断を行います。手術検体では、構造的な全体像での評価が可能となります。病期の確定をして、術後の治療方針に寄与します。
またスライド標本の一部は、バーチャルスライドシステムにより標本をデジタル画像化し、顕微鏡を使用しなくてもモニター画面で鏡検できるように保存しています。デジタル化した標本は、カンファレンス、遠隔診断、セカンドオピニオン、精度管理などに利用されています。




細胞診断
細胞診断検査は生体から採取された個々の細胞を顕微鏡で観察し、良悪性などの病変の性質を診断する検査です。子宮頸部や尿・喀痰・体腔液などの剥離検体、甲状腺・乳腺・リンパ節などからの穿刺吸引検体、気管支鏡や内視鏡での擦過検体、洗浄・ブラッシング検体などが対象となります。細胞診断検査は組織検査に比べ、低侵襲で患者さんへの負担が少ない検査です。また、適応範囲が広く多くの臓器に対応し、検査も迅速性で結果報告までが短いこと、スクリーニング検査としては早期発見などにも有用といった特徴があります。当院では婦人科子宮頸部、尿検体では、液状化検体細胞診(LBC)を採用しています。また体腔液や穿刺検体でも時に併用しています。これは不適正検体の減少、標本均一化による診断精度の向上、細胞の有効活用と追加検査の可能性といった利点があります。この判定は細胞検査士(臨床検査技師)が行い、異常細胞は細胞診専門医(病理医)が確認し報告します。判定は細胞の形態学的特徴に基づき診断しますが、組織構造は僅かしか反映されないので判定が難しいことがあります。


術中迅速診断
術中迅速組織検査は手術中に採取された組織を、短時間で凍結、切片作成・染色し標本を作り、手術方針をその場で決定するための診断を行う検査です。主な目的は、腫瘍なのか、良悪性判定など病変の性状判定、切除断端の確認、リンパ節転移の有無、臓器の適否確認に利用されます。この検査は凍結によるアーチファクトがあり、臓器によっては標本作成に苦慮することがあります。鏡検しやすく美しい標本作りを目指し、正確な診断に寄与します。当院では乳腺領域のリンパ節はOSNA(One-Step Nucleic Acid Amplification)法という転移リンパ節内の腫瘍細胞を分子レベルで迅速に検出する検査法を実施しています。提出されたリンパ節を細かく砕き、遺伝子を抽出し測定する検査です。その際精度向上のため、細胞診検体も作成し一緒に迅速報告しています。細胞検体においては、手術中の体腔液などの術中診断に対応しています。

ONSA法機器
病理解剖
病理解剖とは、亡くなられた患者さんのご遺体を医学的に詳しく調べ、病気の最終的な状態や死因を明らかにする医学的行為です。当院ではご遺族の同意をいただいた場合に、病理解剖を丁寧に実施致します。その後、生前の臨床経過と解剖結果を突き合わせる検討会も定期的に開催し、生前の臨床診断の確認、治療効果の判定、合併症などについて検討され、今後の医療の質の向上などに大きく役立てられます。病理解剖はご遺族のご理解とご協力により成り立ちます。ご協力いただいたご遺族の皆様には深く感謝申し上げます。年度末には、故人のご供養とご遺族の貴重なご意志に感謝し、合同慰霊祭を開催しています。
臨床検査科の主な検査装置
【採血室・採血管準備システム】
・採血採尿受付機(AI-350:テクノメディカ)
・採血管準備システム(BC-ROBO 9000:テクノメディカ)
・呼び出し表示採血台(C-1P タイプ・C-3P タイプ:テクノメディカ)
【血液検査】
・多項目自動血球分析装置 自動標本作製装置(XR3000:シスメックス)
・血液像自動分析装置(DI60:シスメックス)
・血液凝固多項目測定装置(CN6000:シスメックス)
・血沈測定装置(Quick eye-8:テクノメディカ)
【一般検査】
・尿定性分析装置(AUTION MAX AX-4060 AUTION 11 AE-4021:アークレイ)
・尿中有形成分析装置(UF-1500:シスメックス)
・便潜血測定装置(OCセンサー io:栄研化学)
・浸透圧計(OM-6060:三和医科器械)
【生化学・免疫血清検査】
・臨床化学自動分析装置(コバス 8000:ロシュ・ダイアグノスティックス)
・血液ガス自動分析装置(RAPID Point 500:シーメンスヘルスケア)
・免疫測定装置(μTAS wako i30:栄研化学)
・自動グリコヘモグロビン分析装置(HLC-723G9:東ソー)
・自動グルコース分析装置(GA09-RC200C:エイアンドティー)
・ビリルビン測定装置(ビルメーターF:アトムメディカル)
・全自動電気泳動分析装置(エパライザ2:ヘレナ研究所)
【輸血検査】
・全自動輸血検査装置(IH-500:バイオ・ラッド ラボラトリーズ)
【微生物検査】
・MALDIバイオタイパー(sirius one:ブルカージャパン)
・微生物同定感受性分析装置 (DxMマイクロスキャン WalkAway:ベックマン・コールター)
・微生物感受性分析装置 (RAISUS S4:島津ダイアグノスティックス)
・血液培養自動分析装置(バクテアラート VIRTUO:ビオメリュー・ジャパン)
・全自動抗酸菌培養装置(MGIT 320:日本ベクトン・ディッキンソン)
【遺伝子検査】
・全自動遺伝子解析装置(コバスLiat:ロシュ・ダイアグノスティックス)
・全自動遺伝子解析装置(FilmArray Torch:ビオメリュー・ジャパン)
・全自動遺伝子解析装置(GeneXpert GX-IV:ベックマン・コールター)
・リアルタイムPCR装置(Light Cycler96:日本ジェネティクス)
【生理検査】
・心電計(FCP-7541、FCP-8800:フクダ電子)
・ABI[足関節上腕血圧比](VS-3000TN:フクダ電子)
・皮膚灌流圧(SPP-K1:カネカメディックス)
・呼吸機能検査装置(DISCOM21FXⅢ、CHESTAC-8800:チェスト)
・トレッドミル(MAT-3700:フクダ電子)
・肺運動負荷システム[CPX](エアロモニタAE-310S:ミナト医科学)
・脳波(EEG-1284、1214:日本光電)
・筋電図(MEB-2312:日本光電)
・各種超音波装置(EPIQ CVx、IE33:フィリップス・ジャパン ARIETTA850:富士フィルム Aplio i800、verifia、Aplio500:キャノンメディカルシステムズ)
【病理検査】
・自動免疫染色装置(BOND-MAXシステム、BOND-Ⅲシステム:ライカバイオシステムズ)
・自動免疫染色装置(Autostainer Link48:アジレント・テクノロジー)
・自動染色機(Tissue-TEC Prisma、Prisma plus:サクラファインテックジャパン)
・密閉式自動固定包埋装置(Tissue-TEC VIP6-P、VIP6AI:サクラファインテックジャパン)
・自動サンプル準備システムThin Prep(5000、2000:ホロックジャパン)
・遺伝子増幅検出装置(RD-200 OSNA:シスメックス)
・凍結薄切切片標本作成装置クリオスタット(LEICA CM3500 S 2台:ライカバイオシステムズ)
・電子顕微鏡(JEM1010:日本電子)
・バーチャルスライドシステム(VS120:エビデント)
受診について
佐久医療センターは紹介型・
予約制の病院です。
ご本人ではなく、かかりつけ医を通じ、事前に紹介状を送ってください。
診療日
- 平日 8:30~17:00
休診日
土曜日・日曜日・祝日・年末年始















